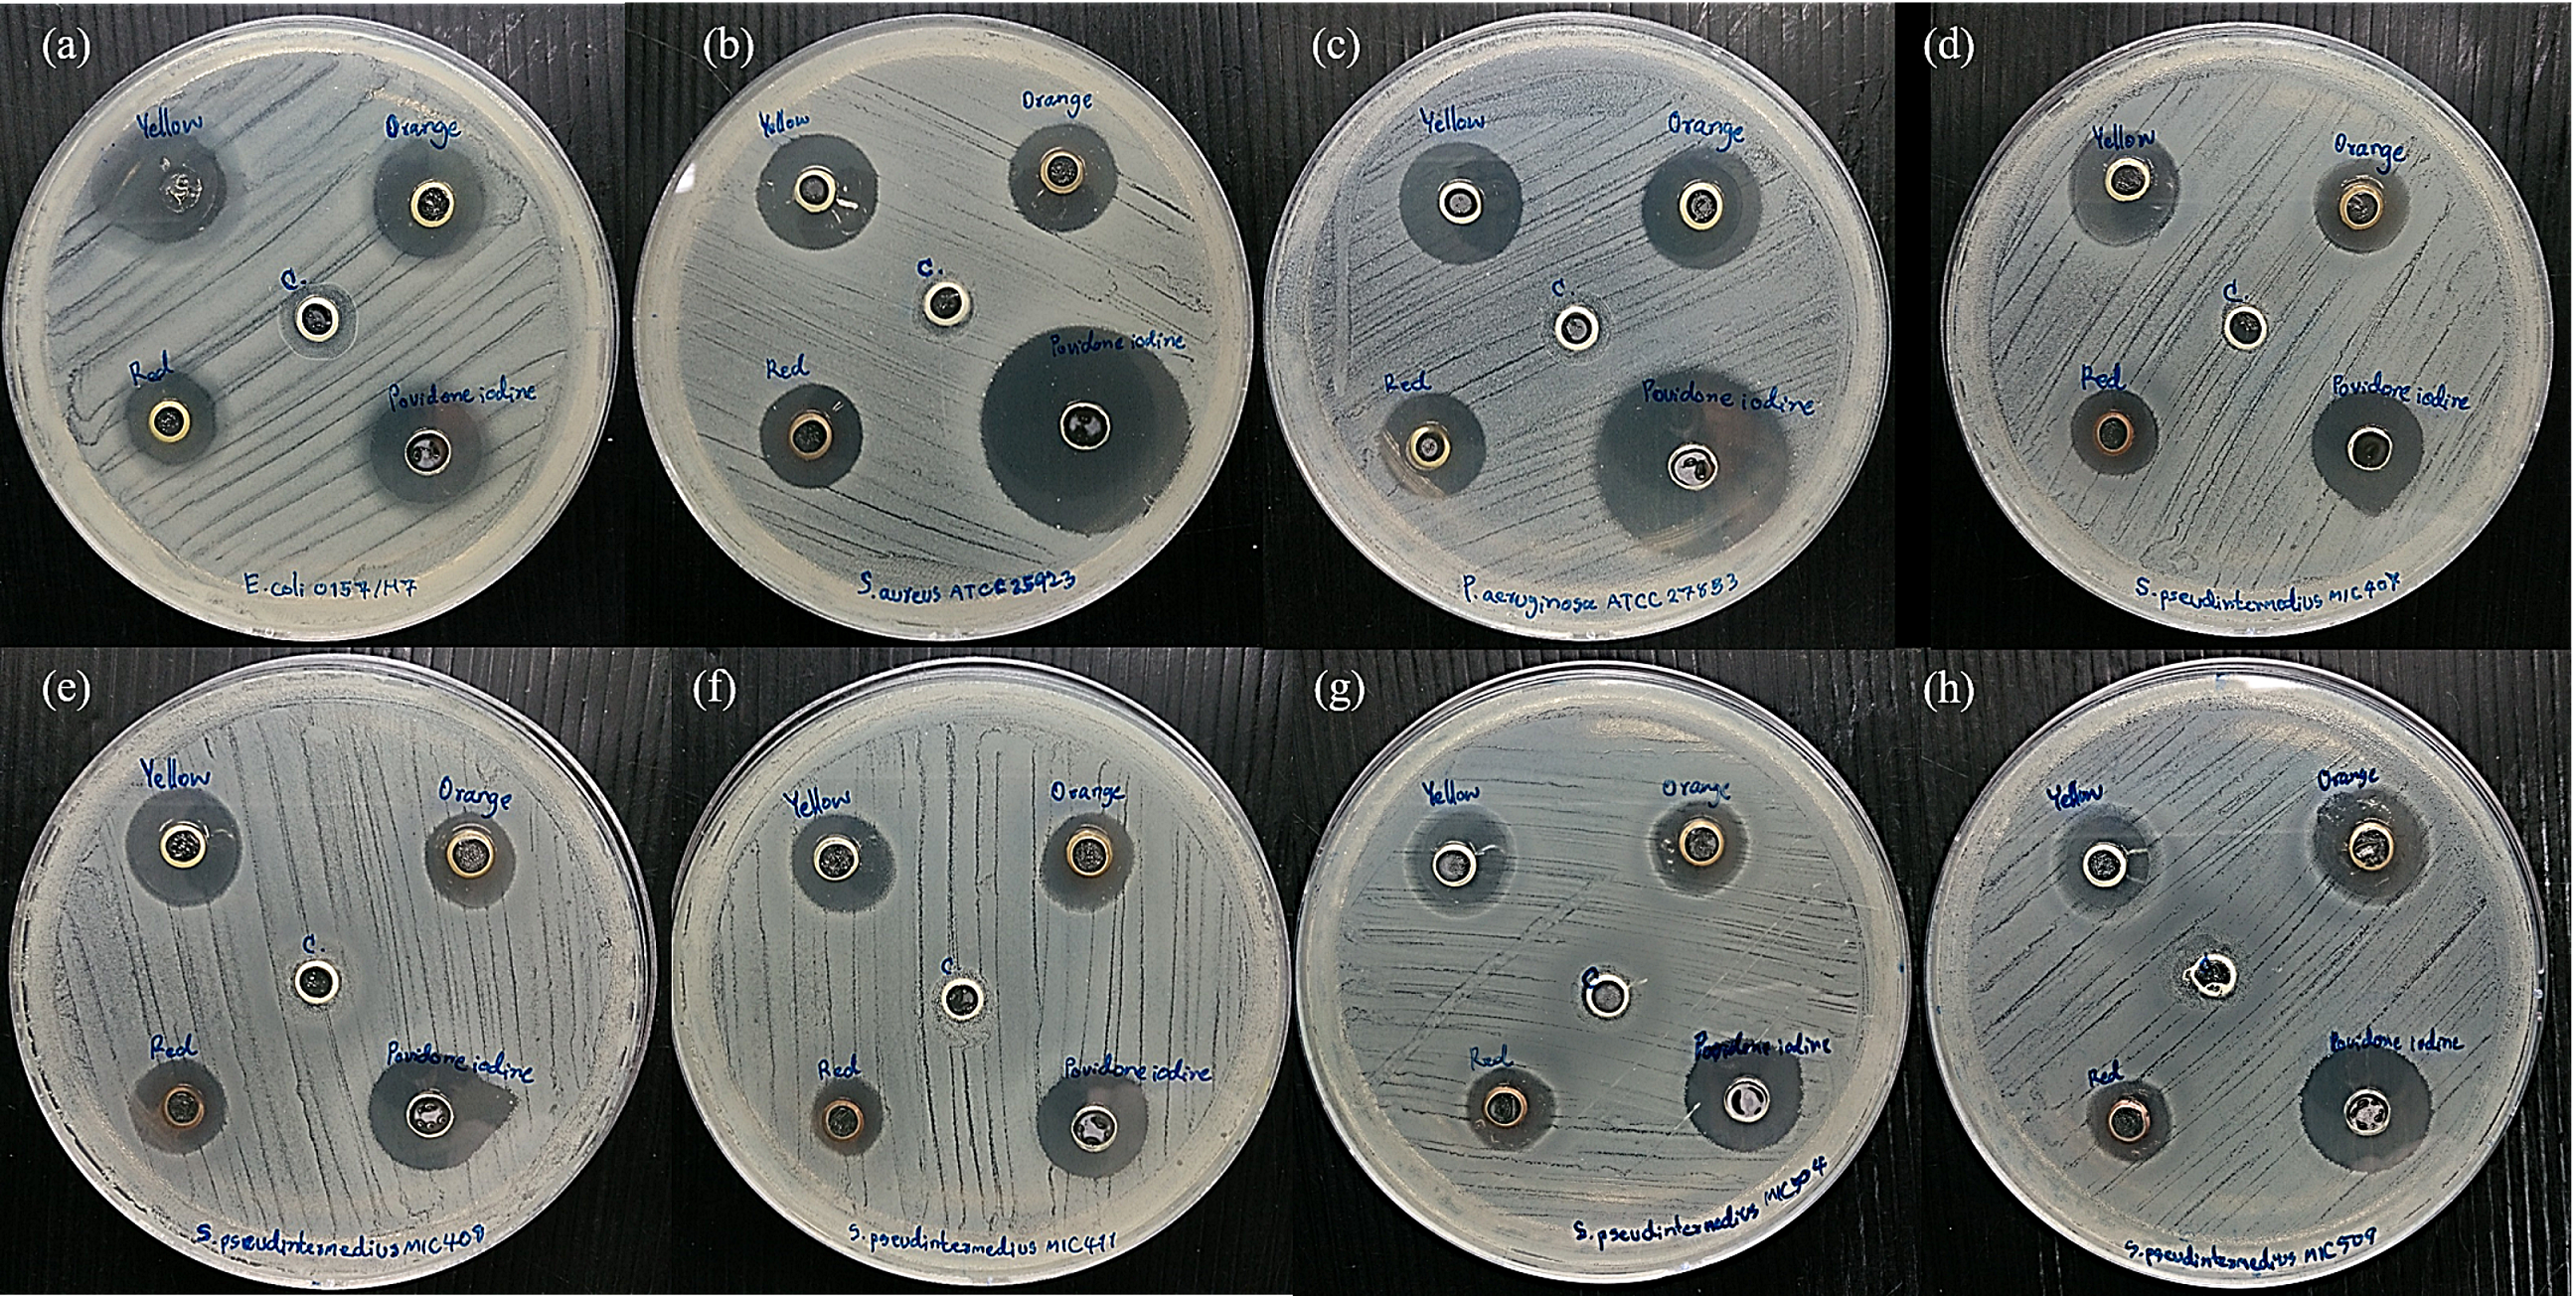
Vetsci 08 00177 g005
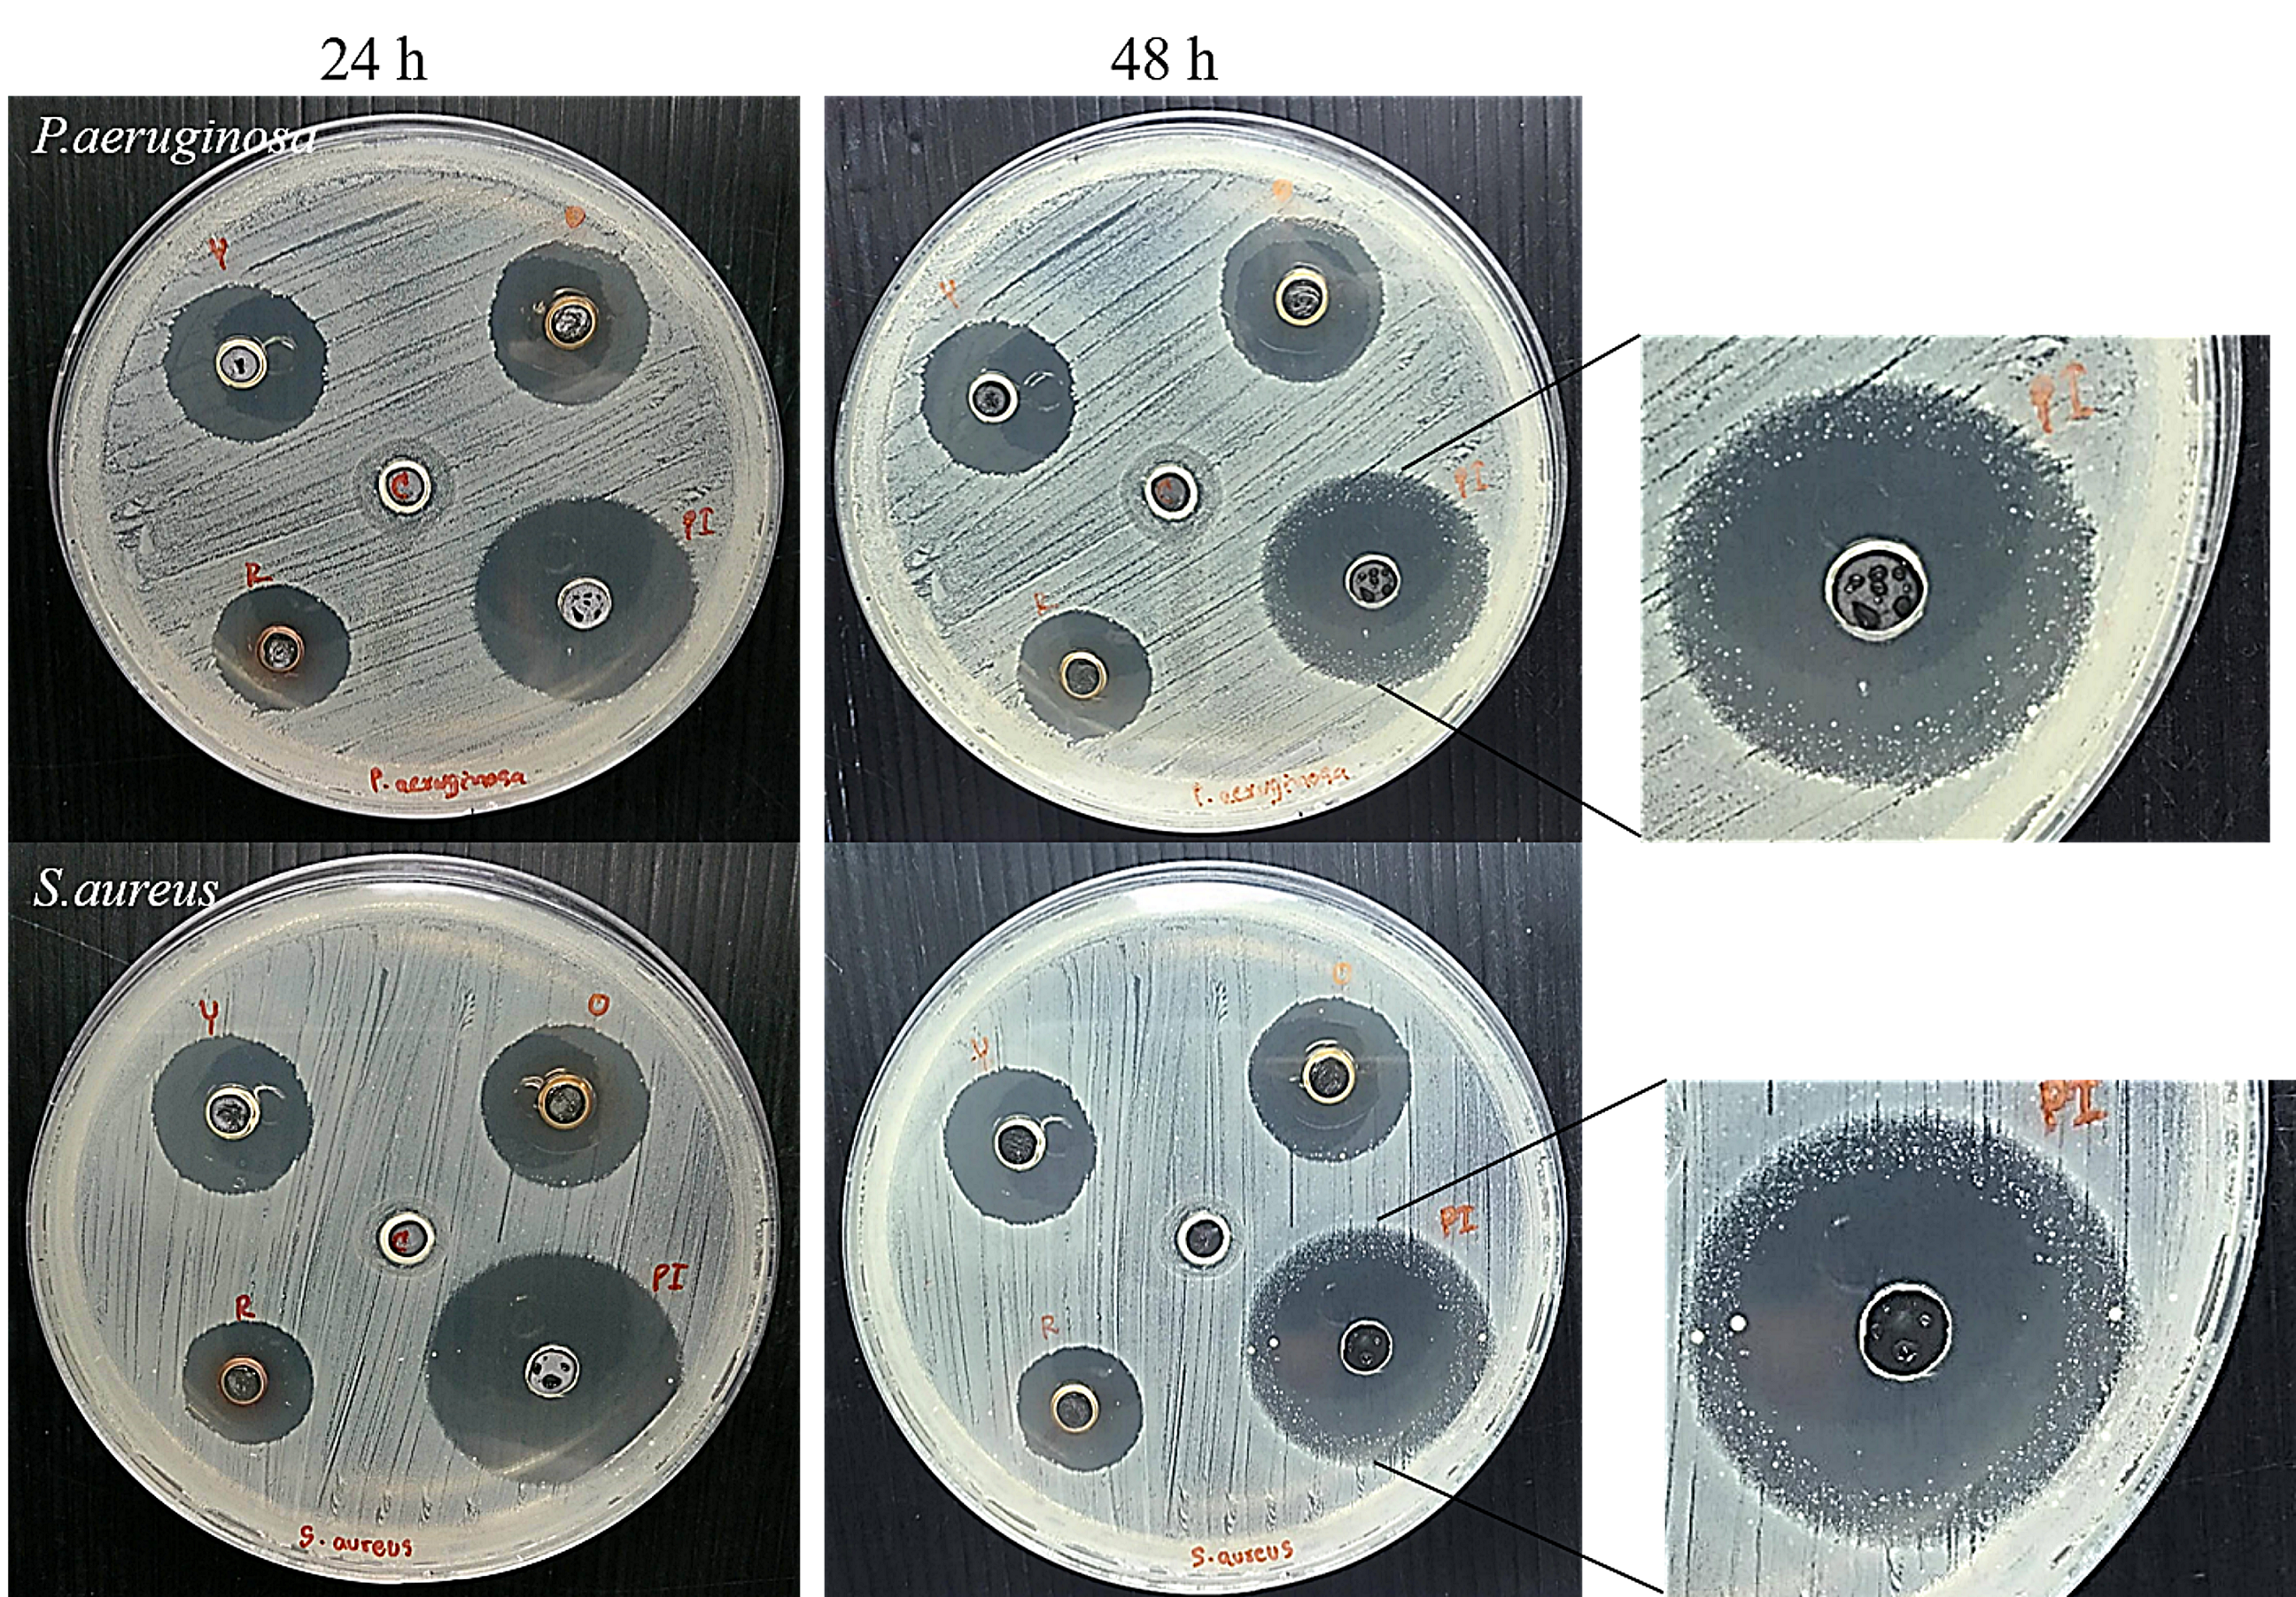
Vetsci 08 00177 g006

A Biological Study of Anisotropic Silver Nanoparticles and Their Antimicrobial Application for Topical Use
Abstract
:1. Introduction
2. Materials and Methods
2.1. Bacterial Strains and Culture Conditions
2.2. Cell Culture
2.3. Characterisation of AgNPs
2.4. Bacterial Susceptibility Test
2.5. Staphylococcus pseudintermedius Cell Morphological Change
2.6. Cytotoxicity Assay
2.7. Preparation and Formulation of the AgNPs Gel
2.8. Antimicrobial Test and the Prolonged Antimicrobial Effect of the AgNP Gel
2.9. Statistical Analysis
3. Results
3.1. Characterisation of AgNPs
3.2. Bacterial Susceptibility to Antimicrobial Agents
3.3. Morphological Changes in Bacterial Cells
3.4. Cytotoxicity Assay
3.5. Antimicrobial Test of the AgNP Gel and Its Prolonged Antimicrobial Effect
4. Discussion
5. Conclusions
Supplementary Materials
Author Contributions
Funding
Institutional Review Board Statement
Informed Consent Statement
Data Availability Statement
Acknowledgments
Conflicts of Interest
References
- Wimmerstedt, A.; Kahlmeter, G. Associated Antimicrobial Resistance in Escherichia Coli, Pseudomonas Aeruginosa, Staphylococcus Aureus, Streptococcus Pneumoniae and Streptococcus Pyogenes. Clin. Microbiol. Infect. 2008, 14, 315–321. [Google Scholar] [CrossRef] [PubMed] [Green Version]
- Saputra, S.; Jordan, D.; Worthing, K.A.; Norris, J.M.; Wong, H.S.; Abraham, R.; Trott, D.J.; Abraham, S. Antimicrobial Resistance in Coagulase-Positive Staphylococci Isolated from Companion Animals in Australia: A One Year Study. PLoS ONE 2017, 12, e0176379. [Google Scholar] [CrossRef] [PubMed]
- Yoon, J.W.; Lee, K.-J.; Lee, S.-Y.; Chae, M.-J.; Park, J.-K.; Yoo, J.-H.; Park, H.-M. Antibiotic Resistance Profiles of Staphylococcus Pseudintermedius Isolates from Canine Patients in Korea. J. Microbiol. Biotechnol. 2010, 20, 1764–1768. [Google Scholar] [PubMed]
- Lee, A.S.; de Lencastre, H.; Garau, J.; Kluytmans, J.; Malhotra-Kumar, S.; Peschel, A.; Harbarth, S. Methicillin-Resistant Staphylococcus Aureus. Nat. Rev. Dis. Prim. 2018, 4, 18033. [Google Scholar] [CrossRef] [PubMed]
- van Duijkeren, E.; Catry, B.; Greko, C.; Moreno, M.A.; Pomba, M.C.; Pyorala, S.; Ruzauskas, M.; Sanders, P.; Threlfall, E.J.; Torren-Edo, J.; et al. Review on Methicillin-Resistant Staphylococcus Pseudintermedius. J. Antimicrob. Chemother. 2011, 66, 2705–2714. [Google Scholar] [CrossRef] [PubMed] [Green Version]
- Devriese, L.A.; Vancanneyt, M.; Baele, M.; Vaneechoutte, M.; De Graef, E.; Snauwaert, C.; Cleenwerck, I.; Dawyndt, P.; Swings, J.; Decostere, A.; et al. Staphylococcus Pseudintermedius Sp. Nov., a Coagulase-Positive Species from Animals. Int. J. Syst. Evol. Microbiol. 2005, 55 Pt 4, 1569–1573. [Google Scholar] [CrossRef] [Green Version]
- Bardiau, M.; Yamazaki, K.; Ote, I.; Misawa, N.; Mainil, J.G. Characterization of Methicillin-Resistant Staphylococcus Pseudintermedius Isolated from Dogs and Cats. Microbiol. Immunol. 2013, 57, 496–501. [Google Scholar] [PubMed]
- Tong, S.Y.C.; Davis, J.S.; Eichenberger, E.; Holland, T.L.; Fowler, V.G., Jr. Staphylococcus Aureus Infections: Epidemiology, Pathophysiology, Clinical Manifestations, and Management. Clin. Microbiol. Rev. 2015, 28, 603–661. [Google Scholar] [CrossRef] [PubMed] [Green Version]
- Bannoehr, J.; Guardabassi, L. Staphylococcus Pseudintermedius in the Dog: Taxonomy, Diagnostics, Ecology, Epidemiology and Pathogenicity. Vet. Dermatol. 2012, 23, 253–266. [Google Scholar] [CrossRef]
- Gortel, K.; Campbell, K.L.; Kakoma, I.; Whittem, T.; Schaeffer, D.J.; Weisiger, R.M. Methicillin Resistance among Staphylococci Isolated from Dogs. Am. J. Vet. Res. 1999, 60, 1526–1530. [Google Scholar]
- Hartantyo, S.H.P.; Chau, M.L.; Fillon, L.; Ariff, A.Z.B.M.; Kang, J.S.L.; Aung, K.T.; Gutiérrez, R.A. Sick Pets as Potential Reservoirs of Antibiotic-Resistant Bacteria in Singapore. Antimicrob. Resist. Infect. Control 2018, 7, 106. [Google Scholar] [CrossRef] [PubMed]
- Chung, I.-M.; Park, I.; Seung-Hyun, K.; Thiruvengadam, M.; Rajakumar, G. Plant-Mediated Synthesis of Silver Nanoparticles: Their Characteristic Properties and Therapeutic Applications. Nanoscale Res. Lett. 2016, 11, 40. [Google Scholar] [CrossRef] [Green Version]
- Franci, G.; Falanga, A.; Galdiero, S.; Palomba, L.; Rai, M.; Morelli, G.; Galdiero, M. Silver Nanoparticles as Potential Antibacterial Agents. Molecules 2015, 20, 8856–8874. [Google Scholar] [CrossRef] [PubMed] [Green Version]
- Rai, M.K.; Deshmukh, S.D.; Ingle, A.P.; Gade, A.K. Silver Nanoparticles: The Powerful Nanoweapon against Multidrug-Resistant Bacteria. J. Appl. Microbiol. 2012, 112, 841–852. [Google Scholar] [CrossRef] [PubMed]
- Paladini, F.; Pollini, M. Antimicrobial Silver Nanoparticles for Wound Healing Application: Progress and Future Trends. Materials 2019, 12, 2540. [Google Scholar] [CrossRef] [Green Version]
- Gurunathan, S.; Choi, Y.-J.; Kim, J.-H. Antibacterial Efficacy of Silver Nanoparticles on Endometritis Caused by Prevotella Melaninogenica and Arcanobacterum Pyogenes in Dairy Cattle. Int. J. Mol. Sci. 2018, 19, 1210. [Google Scholar] [CrossRef] [PubMed] [Green Version]
- Smekalova, M.; Aragon, V.; Panacek, A.; Prucek, R.; Zboril, R.; Kvitek, L. Enhanced Antibacterial Effect of Antibiotics in Combination with Silver Nanoparticles against Animal Pathogens. Vet. J. 2016, 209, 174–179. [Google Scholar] [CrossRef] [PubMed]
- Jamaran, S.; Zarif, B.R. Synergistic Effect of Silver Nanoparticles with Neomycin or Gentamicin Antibiotics on Mastitis-Causing Staphylococcus Aureus. Open J. Ecol. 2016, 06, 452–459. [Google Scholar] [CrossRef] [Green Version]
- Loiseau, A.; Asila, V.; Boitel-Aullen, G.; Lam, M.; Salmain, M.; Boujday, S. Silver-Based Plasmonic Nanoparticles for and Their Use in Biosensing. Biosensors 2019, 9, 78. [Google Scholar] [CrossRef] [PubMed] [Green Version]
- Tang, B.; Li, J.; Hou, X.; Afrin, T.; Sun, L.; Wang, X. Colorful and Antibacterial Silk Fiber from Anisotropic Silver Nanoparticles. Ind. Eng. Chem. Res. 2013, 52, 4556–4563. [Google Scholar] [CrossRef]
- Osonga, F.J.; Akgul, A.; Yazgan, I.; Akgul, A.; Ontman, R.; Kariuki, V.M.; Eshun, G.B.; Sadik, O.A. Flavonoid-Derived Anisotropic Silver Nanoparticles Inhibit Growth and Change the Expression of Virulence Genes in Escherichia coli SM10. RSC Adv. 2018, 8, 4649–4661. [Google Scholar] [CrossRef] [Green Version]
- Tang, B.; Wang, J.; Xu, S.; Afrin, T.; Xu, W.; Sun, L.; Wang, X. Application of Anisotropic Silver Nanoparticles: Multifunctionalization of Wool Fabric. J. Colloid Interface Sci. 2011, 356, 513–518. [Google Scholar] [CrossRef] [PubMed]
- Sangappa, Y.; Latha, S.; Asha, S.; Sindhu, P.; Parushuram, N.; Shilpa, M.; Byrappa, K.; Narayana, B. Synthesis of Anisotropic Silver Nanoparticles Using Silk Fibroin: Characterization and Antimicrobial Properties. Mater. Res. Innov. 2019, 23, 79–85. [Google Scholar] [CrossRef]
- Pal, S.; Tak, Y.K.; Song, J.M. Does the Antibacterial Activity of Silver Nanoparticles Depend on the Shape of the Nanoparticle? A Study of the Gram-Negative Bacterium Escherichia coli. Appl. Environ. Microbiol. 2007, 73, 1712–1720. [Google Scholar] [CrossRef] [Green Version]
- Strommenger, B.; Kettlitz, C.; Werner, G.; Witte, W. Multiplex PCR Assay for Simultaneous Detection of Nine Clinically Relevant Antibiotic Resistance Genes in Staphylococcus Aureus. J. Clin. Microbiol. 2003, 41, 4089–4094. [Google Scholar] [CrossRef] [PubMed] [Green Version]
- Siritongsuk, P.; Hongsing, N.; Thammawithan, S.; Daduang, S.; Klaynongsruang, S.; Tuanyok, A.; Patramanon, R. Two-Phase Bactericidal Mechanism of Silver Nanoparticles against Burkholderia Pseudomallei. PLoS ONE 2016, 11, e0168098. [Google Scholar] [CrossRef] [PubMed]
- Kim, S.-H.; Lee, H.-S.; Ryu, D.-S.; Choi, S.-J.; Lee, D.-S. Antibacterial Activity of Silver-Nanoparticles against Staphylococcus Aureus and Escherichia Coli. Microbiol. Biotechnol. Lett. 2011, 39, 77–85. [Google Scholar]
- Aslantürk, Ö. In Vitro Cytotoxicity and Cell Viability Assays: Principles, Advantages, and Disadvantages; IntechOpen: London, UK, 2018. [Google Scholar]
- Chawalitpong, S.; Srisomsap, C.; Panriansaen, R.; Cherdshewasart, W. Cytotoxic against MDA-MB-231 Breast Cancer Cells by the Rejuvenating Thai Herbal Plants. In Proceedings of the 50th Kasetsart University Annual Conference, Bangkok, Thailand, 31 January–2 February 2012. [Google Scholar]
- Bassetti, S.; Hu, J.; D’Agostino, R.B., Jr.; Sherertz, R.J. Prolonged Antimicrobial Activity of a Catheter Containing Chlorhexidine-Silver Sulfadiazine Extends Protection against Catheter Infections in Vivo. Antimicrob. Agents Chemother. 2001, 45, 1535–1538. [Google Scholar] [CrossRef] [PubMed] [Green Version]
- Rubin, J.E.; Ball, K.R.; Chirino-Trejo, M. Antimicrobial Susceptibility of Staphylococcus Aureus and Staphylococcus Pseudintermedius Isolated from Various Animals. Can. Vet. J. 2011, 52, 153–157. [Google Scholar] [PubMed]
- Heard, S.M.; Grieser, F.; Barraclough, C.G.; Sanders, J.V. The Characterization of Ag Sols by Electron Microscopy, Optical Absorption, and Electrophoresis. J. Colloid Interface Sci. 1983, 93, 545–555. [Google Scholar] [CrossRef]
- Saion, E.; Gharibshahi, E.; Naghavi, K. Size-Controlled and Optical Properties of Monodispersed Silver Nanoparticles Synthesized by the Radiolytic Reduction Method. Int. J. Mol. Sci. 2013, 14, 7880–7896. [Google Scholar] [CrossRef]
- Parnklang, T.; Lertvachirapaiboon, C.; Pienpinijtham, P.; Wongravee, K.; Thammacharoen, C.; Ekgasit, S. H2O2-Triggered Shape Transformation of Silver Nanospheres to Nanoprisms with Controllable Longitudinal LSPR Wavelengths. RSC Adv. 2013, 3, 12886–12894. [Google Scholar] [CrossRef]
- Parnklang, T.; Lamlua, B.; Gatemala, H.; Thammacharoen, C.; Kuimalee, S.; Lohwongwatana, B.; Ekgasit, S. Shape Transformation of Silver Nanospheres to Silver Nanoplates Induced by Redox Reaction of Hydrogen Peroxide. Mater. Chem. Phys. 2015, 153, 127–134. [Google Scholar] [CrossRef]
- Kelly, J.; Keegan, G.; Brennan-Fournet, M. Triangular Silver Nanoparticles: Their Preparation, Functionalisation and Properties. Acta Phys. Pol. A 2012, 122, 337–345. [Google Scholar] [CrossRef]
- Cheon, J.Y.; Kim, S.J.; Rhee, Y.H.; Kwon, O.H.; Park, W.H. Shape-Dependent Antimicrobial Activities of Silver Nanoparticles. Int. J. Nanomedicine. 2019, 14, 2773–2780. [Google Scholar] [CrossRef] [Green Version]
- Osonga, F.J.; Akgul, A.; Yazgan, I.; Akgul, A.; Eshun, G.B.; Sakhaee, L.; Sadik, O.A. Size and Shape-Dependent Antimicrobial Activities of Silver and Gold Nanoparticles: A Model Study as Potential Fungicides. Molecules 2020, 25, 2682. [Google Scholar] [CrossRef]
- Wolny-Koładka, K.; Malina, D. Silver Nanoparticles Toxicity against Airborne Strains of Staphylococcus Spp. J. Environ. Sci. Heal. Part A Toxic Hazard. Subst. Environ. Eng. 2017, 52, 1247–1256. [Google Scholar] [CrossRef]
- Meroni, G.; Soares Filipe, J.F.; Martino, P.A. In Vitro Antibacterial Activity of Biological-Derived Silver Nanoparticles: Preliminary Data. Vet. Sci. 2020, 7, 12. [Google Scholar] [CrossRef] [PubMed] [Green Version]
- Lu, Z.; Rong, K.; Li, J.; Yang, H.; Chen, R. Size-Dependent Antibacterial Activities of Silver Nanoparticles against Oral Anaerobic Pathogenic Bacteria. J. Mater. Sci. Mater. Med. 2013, 24, 1465–1471. [Google Scholar] [CrossRef]
- Zhang, L.; Wu, L.; Si, Y.; Shu, K. Size-Dependent Cytotoxicity of Silver Nanoparticles to Azotobacter Vinelandii: Growth Inhibition, Cell Injury, Oxidative Stress and Internalization. PLoS ONE 2018, 13, e0209020. [Google Scholar] [CrossRef] [Green Version]
- Dobias, J.; Bernier-Latmani, R. Silver Release from Silver Nanoparticles in Natural Waters. Environ. Sci. Technol. 2013, 47, 4140–4146. [Google Scholar] [CrossRef] [Green Version]
- Slavin, Y.N.; Asnis, J.; Häfeli, U.O.; Bach, H. Metal Nanoparticles: Understanding the Mechanisms behind Antibacterial Activity. J. Nanobiotechnology 2017, 15, 65. [Google Scholar] [CrossRef]
- Tsai, A.; Uemura, S.; Johansson, M.; Puglisi, E.V.; Marshall, R.A.; Aitken, C.E.; Korlach, J.; Ehrenberg, M.; Puglisi, J.D. The Impact of Aminoglycosides on the Dynamics of Translation Elongation. Cell Rep. 2013, 3, 497–508. [Google Scholar] [CrossRef] [Green Version]
- Hamida, R.S.; Ali, M.A.; Goda, D.A.; Khalil, M.I.; Al-Zaban, M.I. Novel Biogenic Silver Nanoparticle-Induced Reactive Oxygen Species Inhibit the Biofilm Formation and Virulence Activities of Methicillin-Resistant Staphylococcus Aureus (MRSA) Strain. Front. Bioeng. Biotechnol. 2020, 8, 433. [Google Scholar] [CrossRef]
- Dakal, T.C.; Kumar, A.; Majumdar, R.S.; Yadav, V. Mechanistic Basis of Antimicrobial Actions of Silver Nanoparticles. Front. Microbiol. 2016, 7, 1831. [Google Scholar] [CrossRef] [Green Version]
- Qing, Y.; Cheng, L.; Li, R.; Liu, G.; Zhang, Y.; Tang, X.; Wang, J.; Liu, H.; Qin, Y. Potential Antibacterial Mechanism of Silver Nanoparticles and the Optimization of Orthopedic Implants by Advanced Modification Technologies. Int. J. Nanomedicine 2018, 13, 3311–3327. [Google Scholar] [CrossRef] [Green Version]
- Jeong, Y.; Lim, D.W.; Choi, J. Assessment of Size-Dependent Antimicrobial and Cytotoxic Properties of Silver Nanoparticles. Adv. Mater. Sci. Eng. 2014, 2014, 763807. [Google Scholar] [CrossRef] [Green Version]
- Khalandi, B.; Asadi, N.; Milani, M.; Davaran, S.; Abadi, A.J.N.; Abasi, E.; Akbarzadeh, A. A Review on Potential Role of Silver Nanoparticles and Possible Mechanisms of Their Actions on Bacteria. Drug Res. 2017, 67, 70–76. [Google Scholar] [CrossRef]
- Yin, I.X.; Zhang, J.; Zhao, I.S.; Mei, M.L.; Li, Q.; Chu, C.H. The Antibacterial Mechanism of Silver Nanoparticles and Its Application in Dentistry. Int. J. Nanomed. 2020, 15, 2555–2562. [Google Scholar] [CrossRef] [Green Version]
- Freire, P.L.L.; Albuquerque, A.J.R.; Farias, I.A.P.; da Silva, T.G.; Aguiar, J.S.; Galembeck, A.; Flores, M.A.P.; Sampaio, F.C.; Stamford, T.C.M.; Rosenblatt, A. Antimicrobial and Cytotoxicity Evaluation of Colloidal Chitosan—Silver Nanoparticles—Fluoride Nanocomposites. Int. J. Biol. Macromol. 2016, 93 Pt A, 896–903. [Google Scholar] [CrossRef]
- Perde-Schrepler, M.; Florea, A.; Brie, I.; Virag, P.; Fischer-Fodor, E.; Vâlcan, A.; Gurzău, E.; Lisencu, C.; Maniu, A. Size-Dependent Cytotoxicity and Genotoxicity of Silver Nanoparticles in Cochlear Cells In Vitro. J. Nanomater. 2019, 2019, 6090259. [Google Scholar] [CrossRef] [Green Version]
- Peretyazhko, T.S.; Zhang, Q.; Colvin, V.L. Size-Controlled Dissolution of Silver Nanoparticles at Neutral and Acidic PH Conditions: Kinetics and Size Changes. Environ. Sci. Technol. 2014, 48, 11954–11961. [Google Scholar] [CrossRef]
- Lin, L.; Li, H.; Liu, Y. Release Oscillation in a Hollow Fiber—Part 2: The Effect of Its Frequency on Ions Release and Experimental Verification. J. Low Freq. Noise Vib. Act. Control 2019, 40. [Google Scholar] [CrossRef] [Green Version]
- Valappil, S.P.; Pickup, D.M.; Carroll, D.L.; Hope, C.K.; Pratten, J.; Newport, R.J.; Smith, M.E.; Wilson, M.; Knowles, J.C. Effect of Silver Content on the Structure and Antibacterial Activity of Silver-Doped Phosphate-Based Glasses. Antimicrob. Agents Chemother. 2007, 51, 4453–4461. [Google Scholar] [CrossRef] [Green Version]
- Thomas, R.; Janardhanan, A.; Varghese, R.T.; Soniya, E.V.; Mathew, J.; Radhakrishnan, E.K. Antibacterial Properties of Silver Nanoparticles Synthesized by Marine Ochrobactrum Sp. Braz. J. Microbiol. 2015, 45, 1221–1227. [Google Scholar] [CrossRef] [Green Version]

| Bacteria | Sources |
|---|---|
| E. coli O157:H7 | Human gastrointestinal tract |
| S. aureus ATCC 25923 | Clinical isolate |
| P. aeruginosa ATCC 27853 | Hospital blood specimen |
| * S. pseudintermedius MIC 407 | Crust from skin |
| * S. pseudintermedius MIC 408 | Papule/recurrent pyoderma |
| * S. pseudintermedius MIC 411 | Exudate from wound |
| S. pseudintermedius MIC 504 | Pustule |
| S. pseudintermedius MIC 509 | Deep pyoderma |
| Bacteria | MIC (µg/mL) | MBC (µg/mL) | ||||||||||
|---|---|---|---|---|---|---|---|---|---|---|---|---|
| S1 | S2 | S3 | S4 | S5 | GENT | S1 | S2 | S3 | S4 | S5 | GENT | |
| E. coli O157:H7 | 1–4 | 2–4 | 2–4 | 4–16 | 8–16 | 0.5 | 2–4 | 2–8 | 2–8 | 8–32 | 16–32 | 1 |
| S. aureus ATCC 25923 | 8–16 | 32 | 16–32 | 16–64 | 32–100 | 1–2 | 16–32 | 32 | 32–64 | 100 | 100 | 2 |
| * MIC 407 | 2–16 | 4–32 | 16–32 | 32–64 | 32–100 | 32 | 16 | 4–32 | 16–32 | 32–64 | 32–100 | 32 |
| * MIC 408 | 4–16 | 4–32 | 8–64 | 32–64 | 64–100 | 2–4 | 4–16 | 4–32 | 16–64 | 32–100 | 64–100 | 2–4 |
| * MIC 411 | 2–16 | 4–32 | 16–100 | 32–64 | 32–100 | 16–32 | 4–32 | 8–32 | 32–100 | 32–100 | 64–100 | 16–32 |
| MIC 504 | 2–4 | 4–16 | 16–32 | 16–32 | 32–64 | 0.5 | 2–8 | 4–16 | 32 | 32–64 | 64 | 1–4 |
| MIC 509 | 2–4 | 4–16 | 4–32 | 16–64 | 32–64 | 0.25 | 4–8 | 8–16 | 16–32 | 16–64 | 32 | 0.5 |
| Range of MIC/MBC | 1–16 | 2–32 | 2–100 | 4–64 | 8–100 | 0.25–32 | 2–32 | 2–32 | 2–100 | 8–100 | 16–100 | 0.5–32 |
Publisher’s Note: MDPI stays neutral with regard to jurisdictional claims in published maps and institutional affiliations. |
© 2021 by the authors. Licensee MDPI, Basel, Switzerland. This article is an open access article distributed under the terms and conditions of the Creative Commons Attribution (CC BY) license (https://creativecommons.org/licenses/by/4.0/).
Share and Cite
Thammawithan, S.; Siritongsuk, P.; Nasompag, S.; Daduang, S.; Klaynongsruang, S.; Prapasarakul, N.; Patramanon, R. A Biological Study of Anisotropic Silver Nanoparticles and Their Antimicrobial Application for Topical Use. Vet. Sci. 2021, 8, 177. https://doi.org/10.3390/vetsci8090177
Thammawithan S, Siritongsuk P, Nasompag S, Daduang S, Klaynongsruang S, Prapasarakul N, Patramanon R. A Biological Study of Anisotropic Silver Nanoparticles and Their Antimicrobial Application for Topical Use. Veterinary Sciences. 2021; 8(9):177. https://doi.org/10.3390/vetsci8090177
Chicago/Turabian StyleThammawithan, Saengrawee, Pawinee Siritongsuk, Sawinee Nasompag, Sakda Daduang, Sompong Klaynongsruang, Nuvee Prapasarakul, and Rina Patramanon. 2021. "A Biological Study of Anisotropic Silver Nanoparticles and Their Antimicrobial Application for Topical Use" Veterinary Sciences 8, no. 9: 177. https://doi.org/10.3390/vetsci8090177
APA StyleThammawithan, S., Siritongsuk, P., Nasompag, S., Daduang, S., Klaynongsruang, S., Prapasarakul, N., & Patramanon, R. (2021). A Biological Study of Anisotropic Silver Nanoparticles and Their Antimicrobial Application for Topical Use. Veterinary Sciences, 8(9), 177. https://doi.org/10.3390/vetsci8090177

